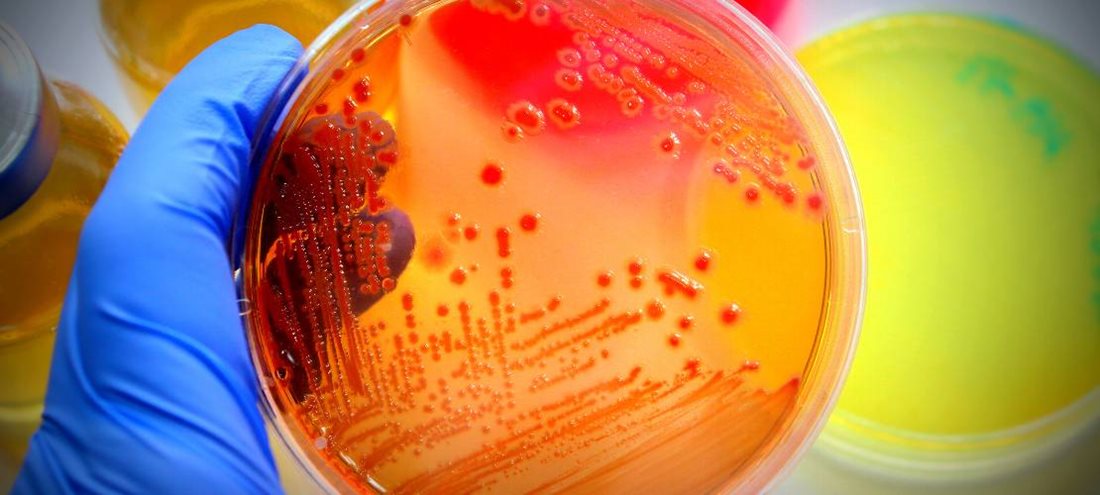

Petit tour d’horizon des plus récentes réalisations des équipes du Centre de recherche du CHU de Québec-Université Laval.
Rayonnement
Les travaux de plusieurs équipes ont fait l’objet d’articles du journaliste Jean Hamann, dans ULaval Nouvelles.
- Commotions cérébrales : des symptômes qui durent
Les récentes recherches de Natalie Le Sage révèlent que le risque de persistance des symptômes de commotion cérébrale 90 jours après l’accident est 26 % plus élevé chez les patients qui ont eu des blessures concomitantes.
Ses travaux ont fait l’objet d’un article et ont aussi été discutées à l’émission Les années lumière de Radio-Canada.
- Cancer du sein : un nouveau risque identifié
Les travaux de l’équipe de Caroline Diorio, dont les recherches portent sur le cancer du sein, a fait l’objet d’un article en lien avec la découverte que les femmes qui ont un tour de taille élevé sont à risque de cancer du sein, même si elles ont un poids santé.
- Une nouvelle classe d’ARN
Patrick Provost et ses collègues rapportent avoir découvert une nouvelle classe d’ARN exceptionnellement courts qui moduleraient de façon inédite l’expression des gènes dans la cellule.
Un cyclothon au profit de la recherche sur les aphasies primaires progressives
Le Cyclothon APP, qui a réuni 30 cyclistes parcourant 250 km au profit de la Chaire de recherche sur les aphasies primaires progressives – Fondation de la famille Lemaire, a été mentionné au Téléjournal Québec (à 20:26). Cet événement a permis d’amasser plus de 17 500 $ qui seront réinvestis en recherche dans l’équipe du Dr Robert Jr Laforce.

Les tests rapides
Dans cet article du journal Le Soleil sur les tests rapides déployés dans les écoles pour le dépistage de la COVID-19, Maude Laberge fait partie des experts qui procurent un éclairage sur cet outil qui sera utilisé chez les enfants qui présentent des symptômes.
Prix et distinctions
- Jacques Simard élu membre de la Société Royale du Canada
Jacques Simard figure parmi les 51 nouveaux membres élus par la Société Royale du Canada (SRC) cette année. Ses études internationales sur le décryptage des risques génétiques du cancer du sein ont été déterminantes pour le développement des outils d’évaluation des risques de la maladie. Ils permettent d’améliorer la prévention et la détection précoce du cancer, notamment grâce à un test de prédisposition génétique pour les gènes BRCA1 et BRCA2 et une approche de dépistage personnalisée. Pour en savoir plus sur cette nomination, consultez le communiqué de la SRC.
- Le Dr Guy Boivin récipiendaire du prix Louis-Pasteur
Le Dr Guy Boivin, clinicien et chercheur au CHU de Québec-Université Laval, s’est vu remettre le prix Louis-Pasteur de la Fédération des médecins spécialistes du Québec (FMSQ), en hommage à ses accomplissements et à sa contribution exceptionnelle au cours de sa carrière de microbiologiste-infectiologue.
